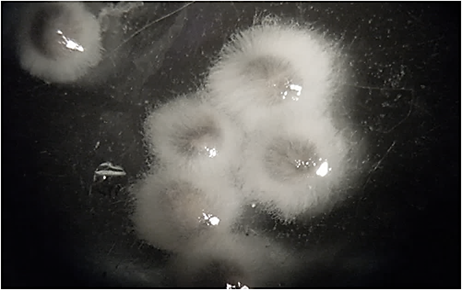

Россия
Россия
Россия
Приведены результаты экспериментальных работ по обработке икры белуги растворами химических веществ (0,9 % хлорид натрия, 0,05 % пероксид водорода, 0,5 % «Монклавит-1», 0,01 % «Йодинол», 0,5 % танин), проведенных с целью подавления роста и развития микромицетов сем. Saprolegniaceae, вызывающих заболевание рыб сапролегниозом. Сапролегниевые микромицеты, поражающие икру при инкубации, молодь и взрослую рыбу, наносят огромный ущерб рыбоводным хозяйствам. Лечение данного заболевания весьма затруднительно в связи с рядом ограничений, введенных в части применения ветеринарных препаратов в аквакультуре. Оценку эффективности применения растворов химических веществ и их воздействия на эмбриональное развитие белуги (Huso huso) и степень заражения эмбрионов микромицетами сем. Saprolegniaceae проводили по рыбоводно-биологическим показателям (доля оплодотворенной икры; доля эмбрионов, зараженных сапролегниевыми микромицетами; доля развивающихся эмбрионов; количество аномально развивающихся ооцитов и доля вылупившихся предличинок) на определенных стадиях развития. Экспериментальные работы проводили в производственных условиях в инкубационном аппарате «Осетр» при соблюдении оптимальных для развития эмбрионов белуги гидрохимических условий. Опытные группы соответствовали экспериментальным концентрациям растворов. Наиболее эффективными растворами, оказывающими ингибирующее действие на рост и развитие микромицетов сем. Saprolegniaceae, является 0,05 %-й раствор пероксида водорода с экспозицией 10 минут и 0,9 %-й раствор хлорида натрия с экспозицией 3 минуты. Данные растворы веществ подавляли рост сапролегниевых микромицетов, не оказывая отрицательного воздействия на эмбриогенез белуги.
икра осетровых рыб, белуга, растворы химических веществ, сапролегниоз, лечебно-про- филактическая обработка, эмбрионы
Введение
Осетровые, в отличие от других видов рыб, характеризуются более высоким уровнем врожденного иммунитета и в естественной среде обитания относительно меньше подвержены заболеваниям [1]. В промышленных условиях с интенсивным темпом производства рыбоводы часто сталкиваются с такими инфекционными заболеваниями осетровых рыб, как микозы, вызываемыми, в частности, микромицетами рода Saprolegnia. Среди грибковых заболеваний сапролегниоз является одним из наиболее распространенных. Особенность возбудителя болезни образовывать устойчивые к неблагоприятным условиям зооспоры способствует их активному распространению как в водной среде, так и в биологических организмах [2]. У сапролегниевых микромицетов токсины не найдены и предполагается, что вред, наносимый ими, выражается в некрозе тканей хозяина в прилегающих к гифам участках [3]. Поражение оплодотворенных ооцитов и эмбрионов сапролегниевыми микромицетами в период инкубации в заводских условиях в ряде случаев может привести к их массовой гибели [4].
Для профилактики и лечения заболеваний рыб рекомендуют около 400 химических препаратов, однако большинство средств, в том числе и все органические красители (фиолетовый «К», малахитовый зеленый, метиленовый зеленый и т. д.), традиционно используемые в аквакультуре для борьбы с сапролегниозом, в настоящее время не входят в Государственный реестр лекарственных средств для ветеринарного применения [4]. Это обусловлено тем, что в результате исследований [5] выявлено токсическое и аккумулирующее действие на икру при ее обработке трифенилметановыми красителями в период инкубации. В настоящее время в Российской Федерации альтернативной замены этим препаратам нет [6].
Поиск средств защиты икры и рыб от микозов ведется в разных направлениях: повышение устойчивости хозяина, поиск антиспорулянтов и подавляющих рост сапролегнии штаммов бактерий и т. д. Преобладают работы, посвященные поиску химических веществ, имеющих фунгицидные и бактерицидные свойств [7–9].
Интенсивное развитие аквакультуры и ограничение использования органических красителей обуславливает необходимость проведения научных исследований, цель которых заключается в оценке эффективности применения химических веществ при лечебно-профилактической обработке икры, зараженной микромицетами сем. Saprolegniacea.
Для достижения цели были поставлены следующие задачи:
1. Изучить рыбоводно-биологические показатели эмбрионального развития белуги до и после лечебно-профилактических обработок икры.
2. Оценить степень заражения икры микромицетами сем. Saprolegniacea в экспериментальных группах после обработок растворами химических веществ.
Материал и методы исследований
Экспериментальные исследования проводили на научно-экспериментальной базе «БИОС» Волжско-Каспийского филиала Всероссийского научно-иссле-
довательского института рыбного хозяйства и океанографии. Объектом исследований являлись оплодотворенные ооциты и развивающиеся эмбрионы белуги (Huso huso) в период инкубации в аппаратах типа «Осетр» в условиях замкнутого водоснабжения.
Для обработки икры использовали растворы пероксида водорода и хлорида натрия, танина и двух лекарственных препаратов: «Йодинол» и «Монклавит-1». Концентрации и продолжительность обработки представлены в табл. 1.
Таблица 1
Table 1
Схема эксперимента и обозначение экспериментальной группы на графиках
в период инкубации икры белуги (Huso huso)
The scheme of the experiment and the designation of the experimental group on the graphs
during the incubation of beluga caviar (Huso huso)
|
№ опытной группы |
Вещество / лекарственное средство |
Концентрация раствора, % |
Экспозиция, мин |
|
1 |
Контроль* |
– |
– |
|
2 |
Натрия хлорид |
0,9 |
3,0 |
|
3 |
«Монклавит-1» |
0,5 |
10,0 |
|
4 |
«Йодинол» |
0,01 |
2,0 |
|
5 |
Пероксид водорода |
0,05 |
10,0 |
|
6 |
Танин |
0,5 |
1,5 |
* Группа, в которой икру не обрабатывали.
Инкубируемая икра распределялась по опытным группам в соответствии с экспериментальными растворами (см. табл. 1) в двух повторностях.
Обработку испытуемыми растворами осуществляли на двух стадиях развития (на 21–22 и 27–28 стадии) [7, 10] методом кратковременных лечебных ванн [8].
Оценку степени воздействия растворов испытуемых веществ на эмбриональное развитие осетровых рыб проводили по следующим параметрам: доля оплодотворенных ооцитов, доля выживших эмбрионов и вылупившихся предличинок [11], доля эмбрионов, зараженных микромицетами сем. Saprolegniaceae, и аномально развивающихся организмов [12]. Определения проводили с использованием микроскопа «Биомед МС-1 Стерео». Оплодотворение определяли на стадии 4 бластомеров – все икринки, которые на данной стадии имеют 4 клетки, считали развивающимися. Количество вылупившихся предличинок определяли весовым методом [11] на электронных весах (НТ-300) с точностью до 0,01 г. Результаты исследований подвергались статистической обработке с использованием программы Microsoft Excel.
Для определения условий в инкубационном цехе ежедневно проводили контроль за основными гидрохимическими показателями воды: температурой воды [13], содержанием в воде кислорода [14], активной реакцией среды рН [15], содержанием в воде аммонийного азота [16], нитритов [17], нитратов [18]. За технологические нормы состояния среды условно приняты обобщенные химические показатели воды хозяйств по выращиванию осетровых рыб и ПДК [19] (табл. 2).
Таблица 2
Table 2
Предельно допустимые значения химических показателей воды хозяйства
при проведении лечебно-профилактических обработок икры осетровых рыб
Maximum permissible values of chemical indicators of water of the farm
when carrying out therapeutic and preventive treatments of sturgeon caviar
|
Химические показатели воды |
Предельно допустимая концентрация (ПДК) |
|
t, оС |
10–24 |
|
O2, мг/л |
не ниже 4,0 |
|
O2, % |
90–100 |
|
рН, ед. |
7,0–8,0 |
|
NH4+, мг/л |
0,5 |
|
NO2–, мг/л |
0,1 (мягкая вода) 0,2 (жесткая вода) |
|
NO3–, мг/л |
1,0 |
Результаты и обсуждение
Условия инкубации икры. При оценке эффективности применения химических веществ для лечебно-профилактической обработки икры белуги (Huso huso) от сапролегниоза и полноценного развития эмбрионов необходим ежедневный контроль гидрохимических условий в процессе инкубации. Показатели гидрохимических условий воды в инкубационном цехе в период развития эмбрионов белуги представлены в табл. 3.
Таблица 3
Table 3
Гидрохимические показатели воды при инкубации икры белуги (Huso huso)
в инкубационных аппаратах типа «Осетр»
Hydrochemical parameters of water during incubation of beluga caviar (Huso huso)
in incubation devices of the “Sturgeon” type
|
Показатель |
Среднее значение, М ± m |
Min значение |
Max значение |
|
t, ºС |
14,3 ± 0,7 |
14,0 |
14,7 |
|
O2, мг/л |
8,9 ± 0,1 |
8,0 |
9,8 |
|
O2, % |
91,1 ± 5,8 |
98,0 |
104 |
|
рН, ед. |
8,3 ± 0,06 |
8,05 |
8,7 |
|
NH4+, мг/л |
0,2 ± 0,01 |
0,09 |
0,26 |
|
NO2–, мг/л |
0,03 ± 0,003 |
0,017 |
0,061 |
|
NO3–, мг/л |
1,57 ± 0,09 |
0,7 |
1,7 |
Установлено, что при оптимальных для развития эмбрионов значениях температуры воды (t) и растворенного кислорода (O2) водородный показатель (рН) и содержание нитратов (NO3–) превышали рекомендуемые нормы вследствие повышенных фоновых показателей воды из водоисточника (рукав Бахтемир), max – 8,7 ед., 1,7 соответственно.
Эмбриональное развитие икры. Наблюдение за эмбриональным развитием включало определение количества нормально развивающихся эмбрионов. Доля оплодотворенной икры в процессе инкубации составляла в среднем 88,8 ± 2,1 %. Полученные показатели не выходили за пределы рекомендуемых (средний процент оплодотворения – 85 %) [20].
Следует отметить, что развитие эмбрионов, полученных в результате использования половых продуктов хорошего рыбоводного качества, а также при соблюдении биотехники инкубации, проходит одновременно, в конце могут встречаться лишь единичные эмбрионы с большими желточными пробками неправильной формы. Если при развитии качественной икры наблюдаются значительные различия в размерах желточной пробки у зародышей, это может свидетельствовать о неблагоприятных условиях инкубации [19]. Также при развитии икры осетровых рыб возможно снижение количества развивающихся эмбрионов за счет элиминации слабых.
При обработке икры экспериментальными растворами различной концентрации и экспозиции может произойти гибель эмбрионов и из-за возможного негативного действия химических веществ или неправильно выбранной экспозиции. В связи с этим необходимо подобрать оптимальную концентрацию раствора и длительность его воздействия.
Соотношение развивающихся эмбрионов белуги до (14–15 стадии развития) и после (34–35 стадии развития) двукратной обработки растворами экспериментальных веществ изображено на рис. 1.

Рис. 1. Соотношение развивающихся эмбрионов в период инкубации икры белуги (Huso huso) в контроле (1),
при воздействии растворов хлорида натрия (2), «Монклавит-1» (3), «Йодинол» (4),
пероксида водорода (5) и танина (6)
Fig. 1. The ratio of developing embryos during incubation of beluga caviar (Huso huso) in the control (1),
when exposed to solutions of sodium chloride (2), “Monclavit-1” (3), “Iodinol” (4),
hydrogen peroxide (5) and tannin (6)
В опытных группах во время инкубации икры белуги при испытании натрия хлорида, «Монклавит-1», танина показатель развития эмбрионов был на уровне контрольной группы (50,5 ± 5,5 %), при испытании «Йодинола» и пероксида водорода – ниже контрольной группы – 38,0 ± 6,0 и 40,0 ± 2,0 % соответственно.
Аномалии в период эмбрионального развития икры. В период инкубации всех групп регистрировали синхронность развития зародышей, стадийный разброс развития не превышал более двух стадий в пробе. Аномально развивающихся эмбрионов регистрировали с 24–25 стадии развития. Их долю определяли на стадиях образования глазных выростов в переднем мозговом пузыре и образования утолщения в области общего зачатка заднетуловищного отдела хвоста (24–25 стадия) и на стадиях единичного и массового вылупления свободных эмбрионов (35–36 стадия).
Изменение доли аномально развивающихся эмбрионов белуги представлены на рис. 2.

Рис. 2. Изменение доли аномально развивающихся эмбрионов в контроле (1),
при воздействии растворов хлорида натрия (2), «Монклавит-1» (3), «Йодинол» (4),
пероксида водорода (5) и танина (6) в период инкубации икры белуги (Huso huso)
Fig. 2. Changes in the proportion of abnormally developing embryos in the control (1),
when exposed to solutions of sodium chloride (2), “Monclavit-1” (3), “Iodinol” (4),
hydrogen peroxide (5) and tannin (6) during incubation of beluga caviar (Huso huso)
Аномалии, регистрируемые у эмбрионов белуги (Huso huso) на 24–25 стадиях развития до обработки растворами, в основном были морфологического характера: искривление тела или хвостового отдела, укороченное тело. Доля аномально развивающихся эмбрионов не превышала 8,5 % и отмечалась в опытной группе с применением раствора «Йодинол».
На этапе массового вылупления (35–36 ст.) разнообразие аномалий, выявленных у эмбрионов, повысилось, добавились следующие патологии: отсутствие глаз или пигмента, а также неправильное развитие желточного мешка. Число выявленных эмбрионов с максимальным значением в контрольной группе не превышало 6 %.
В целом количество эмбрионов белуги (Huso huso) с аномалиями в строении во всех экспериментальных группах составило не более 14 %, что говорит о хорошем качестве икры и об оптимальных условиях инкубации [4].
Определение степени заражения микромицетами сем. Saprolegniacea в период эмбрионального развития икры. Для определения эффективности применения экспериментальных растворов необходимо учитывать степень заражения микромицетами сем. Saprolegniacea. На интенсивность развития сапролегниевых микромицетов на икре влияет как показатель оплодотворения, так и количество мертвой икры, которая поражается микромицетами в первую очередь.
Сапролегниевые микромицеты начинают заражение с неоплодотворенных или мертвых яиц и быстро распространяются на здоровые яйца через положительный хемотаксис, вызывая снижение скорости вылупления. В ходе заражения сначала сапролегниевые микромицеты разрыхляют поверхности оболочек оплодотворенных икринок, происходит их деструкция и вакуолизация. В ряде случаев гифы инвазируют и внутреннее содержимое яиц [8].
В процессе эксперимента пораженные сапролегнией икринки имели белый или сероватый цвет, чем легко отличались от прозрачных, нормально развивающихся (рис. 3).
|
|
|
а б
Рис. 3. Икра белуги (Huso huso), пораженная микромицетами сем. Saprolegniacea:
а – единичное заражение икры; б – массовое поражение икры
Fig. 3. Beluga caviar (Huso huso), affected by sam micromycetes. Saprolegniacea:
a – a single infection of the caviar; б – a massive lesion of the caviar
Заражение инкубируемой икры белуги сапролегниевыми микромицетами регистрировали с 24–25 стадии развития.
Изменение заражения инкубируемой икры белуги представлено на рис. 4.

Рис. 4. Изменение доли зараженных эмбрионов в контроле (1), при воздействии растворов хлорида натрия (2), «Монклавит-1» (3), «Йодинол» (4), пероксида водорода (5) и танина (6)
в период инкубации икры белуги (Huso huso)
Fig. 4. Changes in the proportion of infected embryos in the control (1), when exposed to solutions of sodium chloride (2), “Monclavit-1” (3), “Iodinol” (4), hydrogen peroxide (5) and tannin (6)
during incubation of beluga caviar (Huso huso)
Максимальное заражение икры после двух последовательных воздействий экспериментальных растворов отмечено в группе с использованием раствора «Йодинол» (42,0 ± 8,0 %) и в контрольной группе (39,0 ± 1,0 %), минимальное – в группе с использованием растворов хлорида натрия (17,5 ± 0,5 %), танина (18,0 ± 3,0 %), «Монклавит-1» (21,0 ± 11,0 %) и пероксида водорода (23,5 ± 3,5 %).
Получение предличинок. Завершающим этапом исследований является получение предличинок. Это один из самых важных показателей для оценки эффективности применения лечебно-профилактических средств. По количеству живых подвижных эмбрионов (стадия 35) можно получить представление об ожидаемом выходе личинок. Доля вылупившихся предличинок представлена на рис. 5.

Рис. 5. Доля вылупившихся предличинок белуги (Huso huso) в контроле (1),
при воздействии растворов хлорида натрия (2), «Монклавит-1» (3), «Йодинол» (4),
пероксида водорода (5) и танина (6)
Fig. 5. The proportion of hatched prelarvae of beluga (Huso huso) in the control (1),
when exposed to solutions of sodium chloride (2), “Monclavit-1” (3), “Iodinol” (4),
hydrogen peroxide (5) and tannin (6)
Доля полученных предличинок белуги в большинстве опытных групп была несколько выше значений контрольной группы (25,2 ± 3,5 %), что говорит об отсутствии негативного влияния химических веществ на долю вылупившихся предличинок. Предличинки не отличались размерно-весовыми характеристиками от контрольной группы. Полученная молодь была переведена в пластиковые бассейны цеха с установкой замкнутого водоснабжения для дальнейшего выращивания.
Оценка эффективности применения растворов химических веществ (0,9 % хлорида натрия, 0,05 % пероксида водорода, 0,5 % «Монклавит-1», 0,01 % «Йодинол», 0,5 % танина) для лечебно-профилактической обработки икры белуги (Huso huso) от сапролегниоза проводилась по следующим показателям: эмбриональное развитие, в том числе аномалии, и степень зараженности микромицетами сем. Saprolegniacea.
При применении растворов для обработки эмбрионов белуги были получены следующие результаты:
– 0,9 % хлорида натрия с экспозицией 3 мин – эмбриональное развитие не отличалось от контрольной группы, аномалии составили 0,5 %, доля зараженной икры в 2,2 раза ниже относительно значений в контрольной группе, выход свободных эмбрионов увеличился на 4 %;
– 0,05 % пероксида водорода с экспозицией 10 мин – эмбриональное развитие было ниже относительно контрольной группы, аномалии составили 3,5 %, доля зараженной икры в 1,7 раза ниже относительно значений в контрольной группе, выход свободных эмбрионов увеличился на 3,8 %;
– 0,5 % «Монклавит-1» – эмбриональное развитие не отличалось от контрольной группы, аномалии составили 4,5 %, доля зараженной икры в 1,9 раза ниже относительно значений в контрольной группе, выход свободных эмбрионов увеличился на 2,9 %;
– 0,01 % «Йодинол» – эмбриональное развитие ниже на 12 % относительно контрольной группы, аномалии составили 2,0 %, доля зараженной икры на 3 % выше относительно значений в контрольной группе, выход свободных эмбрионов уменьшился на 6,1 %;
– 0,5 % танин – эмбриональное развитие не отличалось от контрольной группы, аномалии составили 4,0 %, доля зараженной икры в 2,2 раза ниже относительно значений в контрольной группе, выход свободных эмбрионов увеличился на 2,7 %.
Заключение
В результате из всех испытуемых растворов наиболее эффективными являются 0,05 %-й раствор пероксида водорода с экспозицией 10 мин и 0,9 %-й хлорида натрия с экспозицией 3 мин, обработка которыми позволила снизить долю зараженных эмбрионов на 34–35 стадии развития и повысить выход предличинок белуги на 3,8–4 %.
1. Борисова М. Н., Пичугина Т. Д., Завьялова Е. А., Дрошнев А. Е., Коломыцев С. А. Болезни рыб. Обзор эпизоотической ситуации за 2006 год. // Ветеринарная жизнь. 2007. № 14. С. 2-3.
2. Исаева Н. М., Давыдов О. Н., Дудка И. С., Неборачек И. С. Микозы и микотоксикозы рыб. Киев: Изд-во ин-та зоологии НАН Украины, 1995. 168 с.
3. Castell J. D., Tiews K. Report of the EIFAC, IUS and ICES Worcing Group on the standardization of the methodology in fish nutrition research // EIFAC Tech. pap. (Hamburg, Federal Republic of Germany, March 21-23, 1979). Hamburg, 1979. N. 36. P. 1-24.
4. Баринова В. В. Технологические аспекты повышения эффективности инкубации икры осетровых видов рыб: дис. … канд. с.-х. наук. Астрахань, 2022. 138 с.
5. Лаврухина О. И., Амелин В. Г., Прохватилова Л. Б., Ручнова О. И. Риски загрязнения пищевых продуктов на различных стадиях их производства // Ветеринария сегодня. 2017. № 3 (22). С. 33-40.
6. Головин П. П., Романова Н. Н., Головина Н. А., Вараксина В. В. Проблемы профилактики и терапии заболеваний рыб в хозяйствах аквакультуры: современные требования и возможность реализации // Состояние и пути развития аквакультуры в Российской Федерации в свете импортозамещения и обеспечения продовольственной безопасности страны: материалы II Национ. науч.-практ. конф. (Санкт-Петербург, 13-15 сентября 2017 г.). Саратов: ООО «ЦеСАин», 2017. С. 14-20.
7. Нечаева Т. А. Оценка эффективности применения Монклавита-1 с целью повышения сохранности инкубируемой икры радужной форели и защиты ее от сапролегниоза // Вопр. нормативно-правового регулирования в ветеринарии. 2009. № 4. С. 41-43.
8. Рахконен Р., Веннерстрем П., Ритамяки П., Каннел Р. Здоровая рыба. Профилактика, диагностикa и лечение болезней. Хельсинки: Nykypaino, 2012. 180 с.
9. Баринова В. В., Бахарева А. А., Баталова Р. Р. Определение степени воздействия растворов химических веществ разной концентрации на рост и развитие культуры микромицетов сем. Saprolegniaceae «in vitro» // Вестн. Астрахан. гос. техн. ун-та. Сер.: Рыбное хозяйство. 2020. Вып. 4. С. 121-131.
10. Детлаф Т. А., Гинзбург А. С. Зародышевое развитие осетровых рыб (севрюги, осетра и белуги) в связи с вопросами их разведения. М.: Изд-во Акад. наук СССР, 1954. 228 с.
11. Сборник инструкций и нормативно-методических указаний по промышленному разведению осетровых рыб в Каспийском и Азовском бассейнах. М.: Изд-во ВНИРО, 1986. 271 с.
12. Акимова Н. В., Горюнова В. Б., Микодина Е. В., Никольская М. П., Рубан Г. И., Соколова С. А., Шагаева В. Г., Шатуновский М. И. Атлас нарушений в гаметогенезе и строении молоди осетровых. М.: Изд-во ВНИРО, 2004. 120 с.
13. РД 52.24.496-2018. Методика измерений температуры, прозрачности и определения запаха воды. Ро-стов н/Д.: Изд-во Гидрохим. ин-та, 2018. 10 с.
14. РД 52.24.419-2005. Массовая концентрация растворенного кислорода в водах. Методика выполнения измерений йодометрическим методом. Ростов н/Д.: Федеральная служба России по гидрометеорологии и мониторингу окружающей среды, 2005. 21 с.
15. ПНД Ф 14.1:2:3:4.121-97. Количественный химический анализ вод. Методика выполнения измерений pH в водах потенциометрическим методом. М.: ФЦАО, 2016. 7 с.
16. ПНД Ф 14.1:2:3.1-95. Количественный химический анализ вод. Методика измерений массовой концентрации ионов аммония в природных и сточных водах фотометрическим методом с реактивом Несслера. М.: ФЦАО, 2017. 24 с.
17. РД 52.24.381-2017. Массовая концентрация нитритов в водах. Методика выполнения измерений фотометрическим методом с реактивом Грисса. Ростов н/Д.: Изд-во Гидрохим. ин-та, 2017. 21 с.
18. РД 52.24.380-2017. Массовая концентрация нитратов в водах. Методика выполнения измерений фотометрическим методом с реактивом Грисса после восстановления в кадмиевом редукторе. Ростов н/Д.: Изд-во Гидрохим. ин-та, 2017. 28 с.
19. Чебанов М. С., Галич Е. В. Руководство по искусственному воспроизводству осетровых рыб // Технические доклады ФАО по рыбному хозяйству и аквакультуре. Анкара: ФАО, 2011. № 558. 297 с.
20. О внесении изменений в Методику расчета объема добычи (вылова) водных биологических ресурсов, необходимого для обеспечения сохранения водных биологических ресурсов и обеспечения деятельности рыбоводных хозяйств, при осуществлении рыболовства в целях аквакультуры (рыбоводства), утвержденную приказом Минсельхоза России от 30 января 2015 года № 25: приказ Министерства сельского хозяйства Российской Федерации от 25 августа 2015 г. № 377. URL: http://www.consultant.ru/document/cons_doc_LAW_188208/2ff7a8c72de3994f30496a0ccbb1ddafdaddf518/ (дата обращения: 25.01.2023).